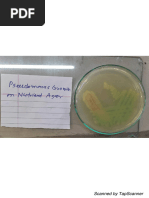

100% found this document useful (1 vote)
126 views19 pagesNotes For Operators in C
An operator is a symbol that tells the compiler to perform a certain mathematical or logical manipulation. Operators are used in programs to manipulate data and variables. C operators can be classified into following types: Arithmetic operators. Relational operators.
Uploaded by
Jeya PerumalCopyright
© © All Rights Reserved
We take content rights seriously. If you suspect this is your content, claim it here.
Available Formats
Download as PDF, TXT or read online on Scribd
100% found this document useful (1 vote)
126 views19 pagesNotes For Operators in C
An operator is a symbol that tells the compiler to perform a certain mathematical or logical manipulation. Operators are used in programs to manipulate data and variables. C operators can be classified into following types: Arithmetic operators. Relational operators.
Uploaded by
Jeya PerumalCopyright
© © All Rights Reserved
We take content rights seriously. If you suspect this is your content, claim it here.
Available Formats
Download as PDF, TXT or read online on Scribd
/ 19